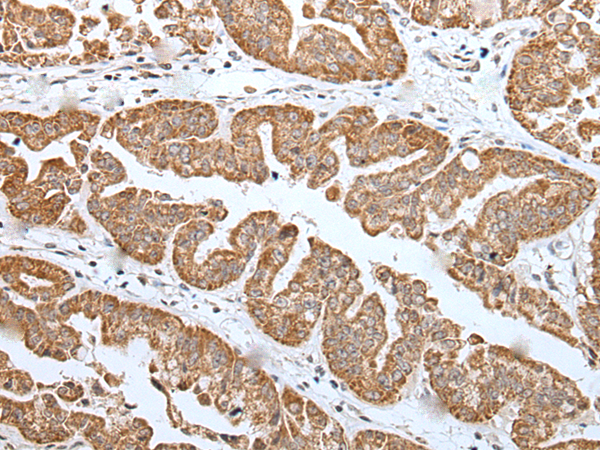

-
分类: 科研抗体货号: P12321别名: TANGO13B应用: IHC反应种属: Human
-
分类: 科研抗体货号: P12301别名: ANG1; NET47; DHCR14A应用: WB,IHC反应种属: Human, Mouse
-
分类: 科研抗体货号: P12320别名: TANGO13A应用: IHC反应种属: Human, Mouse, Rat
-
分类: 科研抗体货号: P12300别名: NET6; NET-6; TM4SF13应用: WB,IHC反应种属: Human, Mouse, Rat
-
分类: 科研抗体货号: P12319别名:应用: IHC反应种属: Human
-
分类: 科研抗体货号: P12297别名: LIN41; LIN-41应用: IHC反应种属: Human, Mouse, Rat
-
分类: 科研抗体货号: P12317别名: D54; TPD54应用: WB,IHC反应种属: Human, Mouse
-
分类: 科研抗体货号: P12328别名: PLOSL2; TREM-2; Trem2a; Trem2b; Trem2c应用: WB反应种属: Human, Mouse
-
分类: 科研抗体货号: P12316别名: PIG11应用: WB,IHC反应种属: Human, Mouse, Rat
-
分类: 科研抗体货号: P12327别名: TIG1; CAG7A; CTG7A; PCQAP; TIG-1; TNRC7; ARC105应用: IHC反应种属: Human, Mouse

鄂公网安备42018502007531号
鄂公网安备42018502007531号

